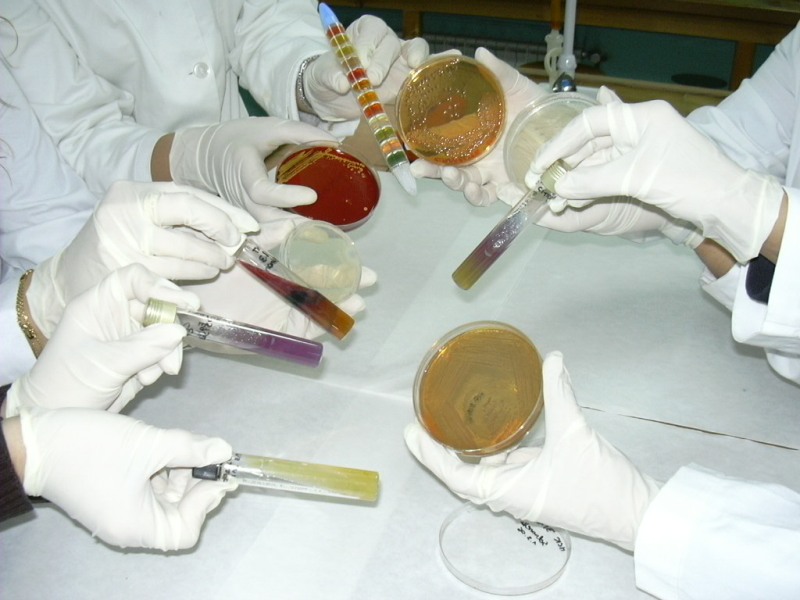

CFGS Laboratori Clínic i Biomèdic
Activitats CF Laboratori Clínic i Biomèdic
- Jornades FP Challenge 2026 19-03-2026
- VISITA AL BANC DE SANG I TEIXITS 1RLCB 11-02-2025
- 1r Laboratori. Sortida Humans Bodies. 27/11/19 11-02-2025
- Donació de sang 2020 09-03-2020
- Medlab 18/19 2nLCB 05-10-2018
Tècnic en Laboratori Clínic i Biomèdic
A Les Vinyes disposem de tres laboratoris equipats amb centrífugues, microscopis òptics, micropipetes, pipetes automàtiques, autoclau, espectrofotòmetres, termociclador, incubador de cèl·lules, microscopi de fluorescència i tot tipus d’assajos per determinar paràmetres biològics. Els equips de què disposem ens permeten dur a terme pràctiques de gran qualitat en els àmbits de l’Hematologia, Microbiologia, Biologia molecular i cultius cel·lulars, Bioquímica i Tècniques instrumentals bàsiques.
Descripció
Aquest cicle formatiu permet, l’estudi d’analítiques de mostres biològiques, interpretant i valorant els resultats obtinguts, actuant sota normes de qualitat, aplicant les regles de seguretat d’un laboratori i les mediambientals.
Durada i horaris
Cicle de 2000 hores repartides en 2 cursos acadèmics amb horari de 8 a 14:30h.

Què estudiaràs?
 |
Mòduls impartits:
|
|
|
Sortides professionals
|
Sortides acadèmiquesAccés a estudis universitaris de grau relacionats amb el cicle: Infermeria, Microbiologia, Genètica, ...
|
Centres de pràctiques col·laboradors
Pràctiques en empreses de Santa Coloma, Badalona i Barcelona:![]()
Currículum Oficial de Tècnic en Laboratori Clínic i Biomèdic
Informació més recent (Departament d'Educació)

US HI ESPEREM!
Torna a...
| <<< | Sanitaris |
| << | Cicles Formatius |











